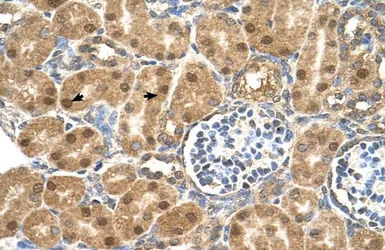

PTGDS antibody, N-term
Cat. No. GTX46255
Cat. No. GTX46255
-
HostRabbit
-
ClonalityPolyclonal
-
IsotypeIgG
-
ApplicationsWB IHC-P
-
ReactivityHuman